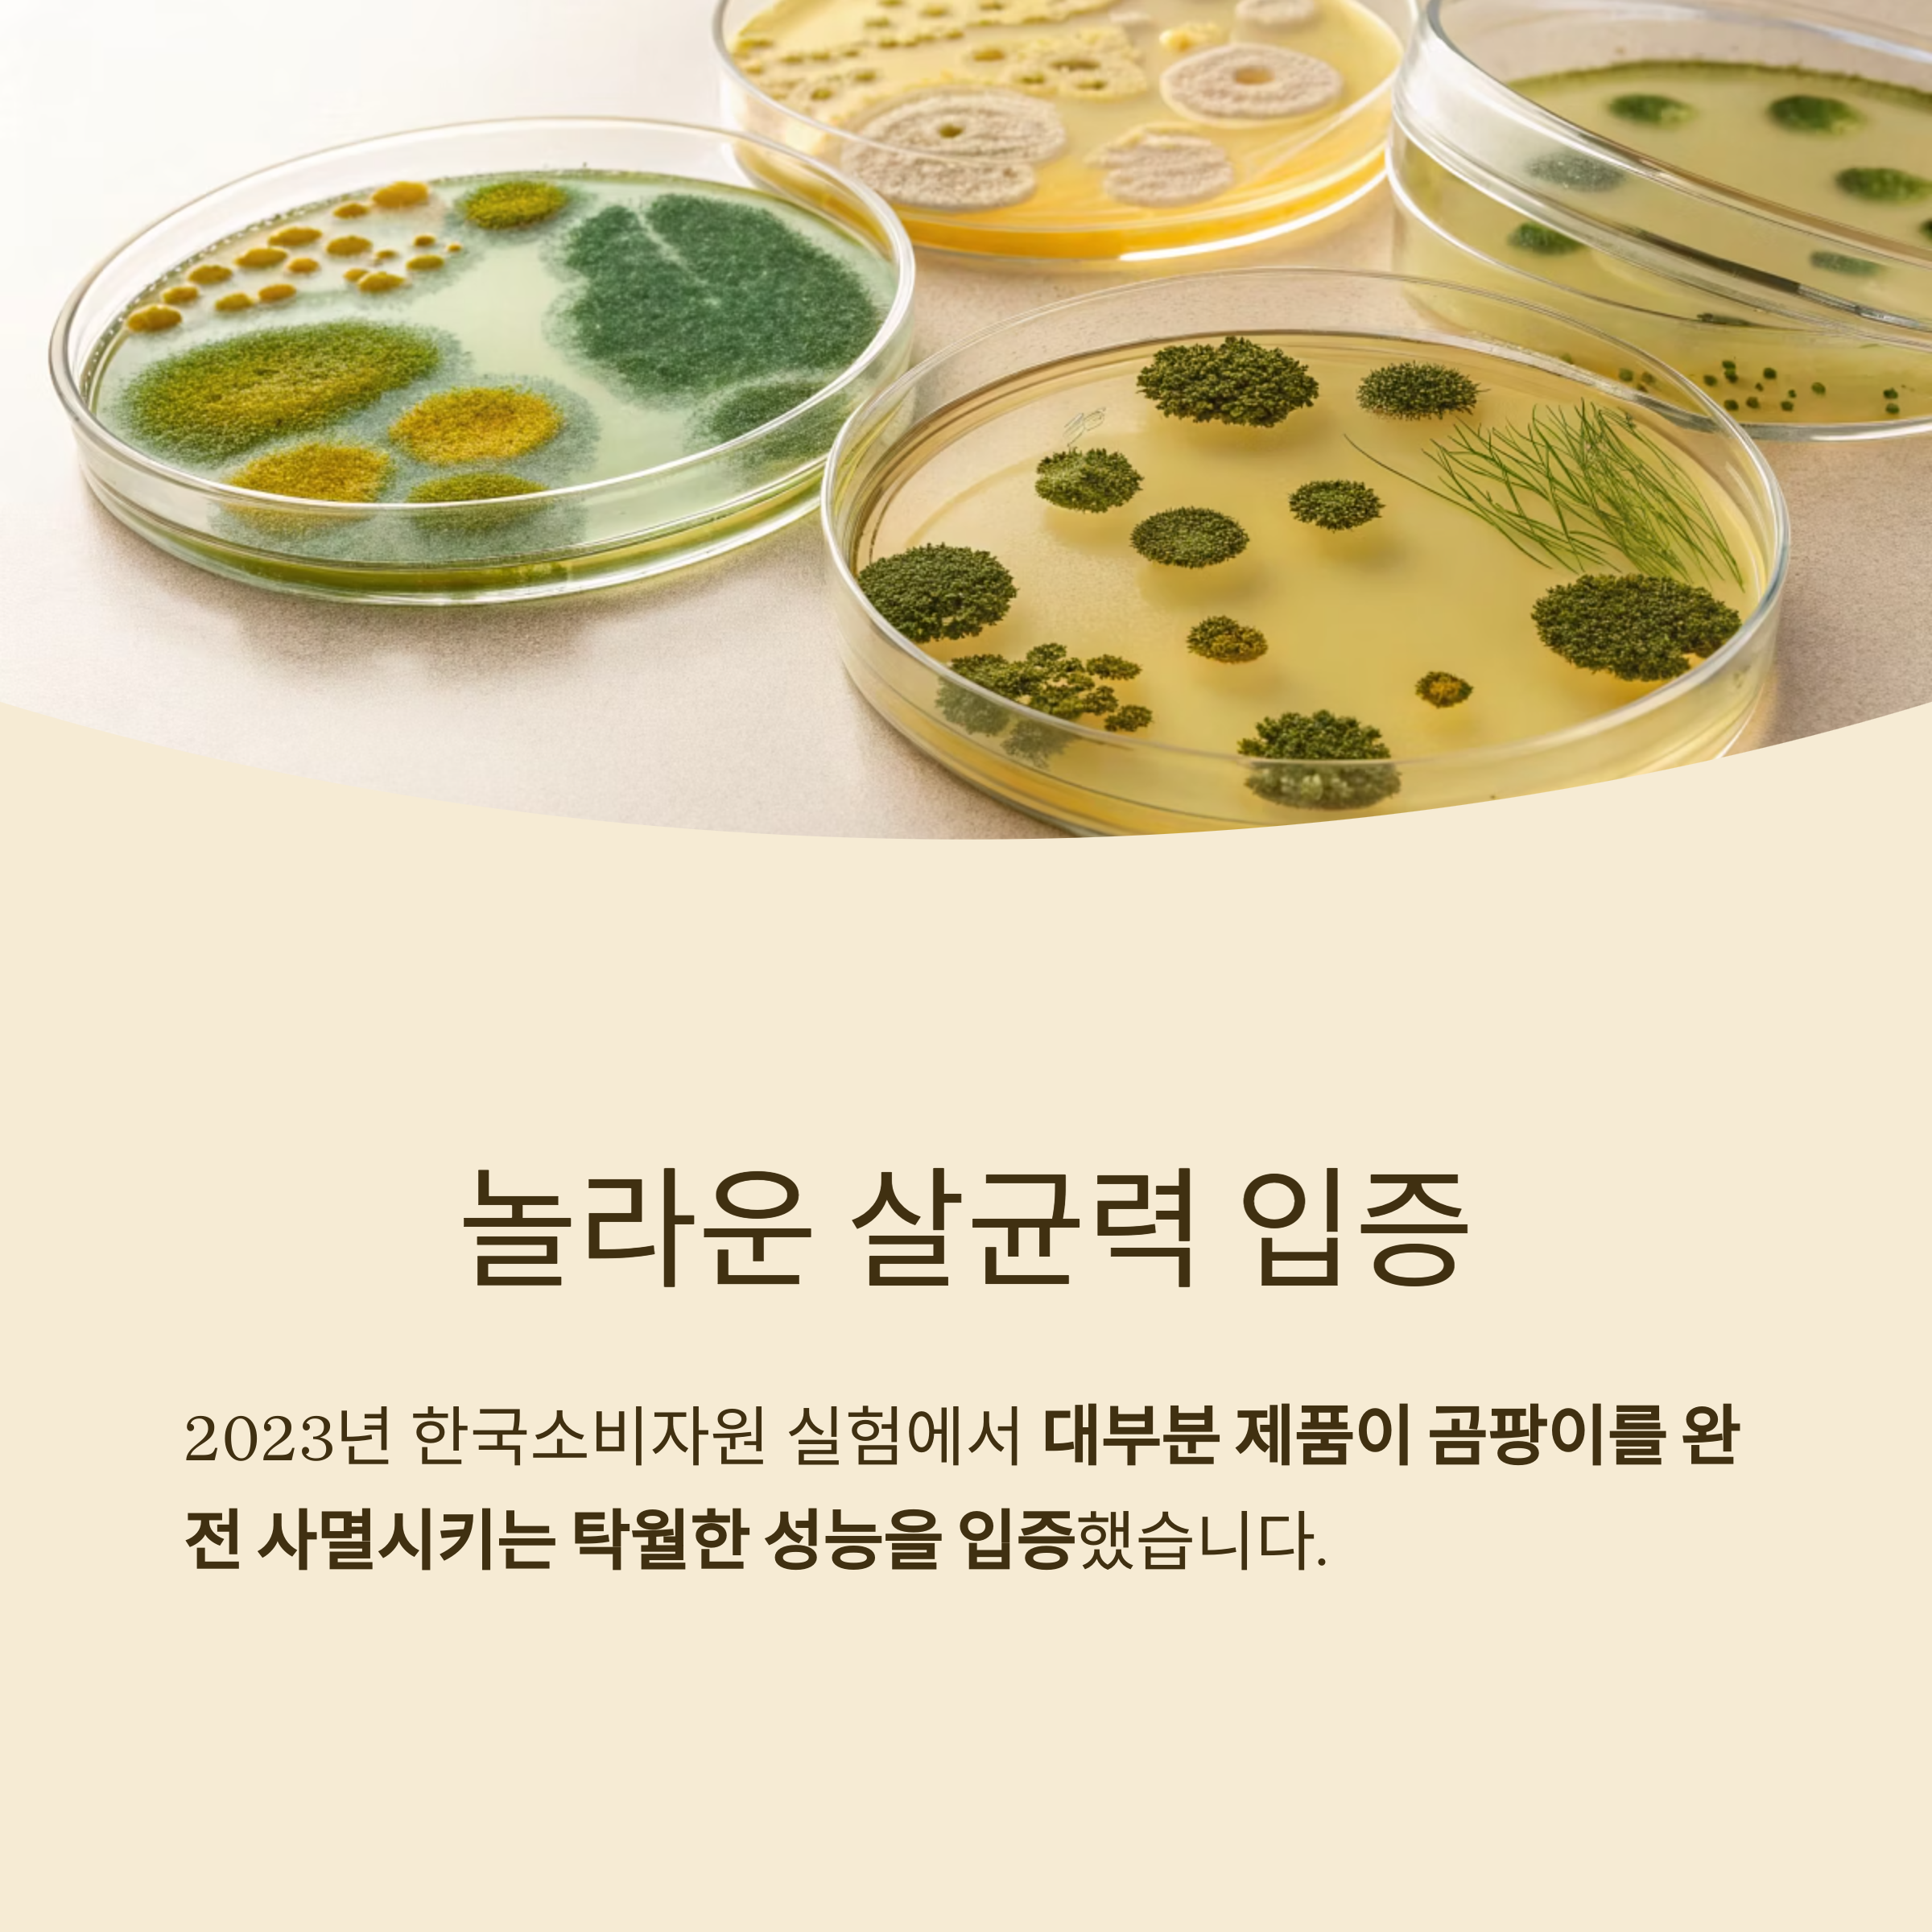

2025년 최신 곰팡이 제거제 성능 분석
곰팡이 제거제는 이제 단순 청소용품이 아닙니다.
강력한 살균력과 안전성을 동시에 갖춘 필수 생활 아이템으로 자리 잡았습니다.
곰팡이 제거제, 얼마나 효과적인가?
2023년 한국소비자원이 진행한 욕실 곰팡이 제거제 8종 실험에서
대부분 제품이 곰팡이를 완전 사멸시키는 탁월한 성능을 입증했습니다.
15분 동안 오염 표면에 접촉시키는 간단한 실험을 통해 곰팡이 증식 여부를 확인하는 방식이었습니다.
완전 사멸 입증 제품

실험에서 곰팡이 제거 성능이 가장 우수했던 제품 6종은 다음과 같습니다.
강력한 곰팡이제거제
무균무때 곰팡이용
브레프 파워 곰팡이용
생활공작소 뿌리는 곰팡이제거제
유한락스 곰팡이제거제
홈스타 뿌리는 곰팡이 싹
이 제품들은 모두 15분 내 곰팡이를 완전히 제거하는 효과를 보였습니다.
가격 차이 최대 16.7배

곰팡이 제거제의 가격은 100mL 기준 최저 217원부터 최고 3,633원까지 다양했습니다.
경제성을 중시한다면 유한락스 곰팡이제거제와 홈스타 제품이 매력적입니다.
그러나 고가 제품이 항상 성능이 뛰어난 것은 아니므로 성능, 가격, 사용 편의성을 종합적으로 고려하는 것이 중요합니다.
안전성과 환경성도 합격점
한국소비자원은 14개 유해물질과 26개 알레르기 유발 가능 물질을 검사했으며 모든 제품이 기준에 적합했습니다.
용기 내구성에서도 전 제품이 이상이 없었고, 포장재 재활용성은 5개 제품이 '우수' 평가를 받았습니다.
곰팡이 제거제 vs 제습기

곰팡이 제거제와 제습기는 용도와 기능에서 뚜렷한 차이를 보입니다.
아래 표를 통해 비교해보겠습니다.
항목 곰팡이 제거제(스프레이/젤) 제습기
| 곰팡이 직접 제거 | 즉각적, 완전 사멸(15분 내 효과) | 직접 제거 불가 |
| 예방 효과 | 일시적, 재발 방지에는 한계 | 습도 조절로 곰팡이 발생 억제 |
| 가격 | 100mL당 217~3,633원 | 10~50만원 |
| 유해물질 | 기준 적합 | 해당 없음 |
| 사용 편의성 | 뿌리고 닦아내는 간편 사용 | 설치 후 자동 운전 |
| 세척 성능 | 물때·비누때 일부 제거 | 해당 없음 |
| 재활용성 | 5개 제품 우수 등급 | 제품별 상이 |
핵심 결론 : 이미 번식한 곰팡이는 제거제가, 예방은 제습기가 효과적입니다.
소비자 리뷰로 본 '뿌곰젤'의 인기

2025년 소비자 리뷰에서 가장 주목받은 제품 중 하나는 뿌곰젤 곰팡이 제거제입니다.
특징 내용
| 형태 | 젤 타입으로 수직면 사용 가능 |
| 사용법 | 저녁에 뿌리고 다음날 닦기 |
| 소비자 평 | "다른 제품보다 효과 좋다" |
| 가격 | 29,800원 (2025년 4월 기준) |
| 단점 | 일부 방송처럼 완벽히 지워지지 않는 경우 존재 |
젤 타입은 특히 천장, 벽 등 흘러내림 없이 강력한 부착 효과로 인기를 끌고 있습니다.
천연 곰팡이 제거법도 여전히 활용 가능

일부 소비자는 자연 친화적 방법도 선호합니다. 아래와 같은 방법이 대표적입니다.
방법 사용법
| 베이킹소다+식초 | 1:1 혼합, 분무 후 10분에서 15분 후 솔질 |
| 락스 희석액 | 1:1 희석, 10분에서 20분 방치, 환기 필수 |
| 과산화수소 | 직접 분사, 30분 후 닦음 |
| 옥수수 삶은 물+레몬 | 천연 계면활성제+산성 성분 활용 |
단, 락스와 산성 세제의 혼합은 염소가스 발생 위험이 있어 절대 금지해야 합니다.
곰팡이 제거제 선택 가이드 정리

성능 우수 제품
강력한 곰팡이제거제, 무균무때 곰팡이용, 브레프 파워 곰팡이용, 생활공작소 뿌리는 곰팡이제거제, 유한락스 곰팡이제거제, 홈스타 뿌리는 곰팡이 싹
경제성 우수 제품
유한락스 곰팡이제거제, 홈스타 뿌리는 곰팡이 싹
재활용성 우수 제품
강력한 곰팡이제거제, 무균무때 곰팡이용, 브레프 파워 곰팡이용, 생활공작소 뿌리는 곰팡이제거제, 홈스타 뿌리는 곰팡이 싹
주의사항
산성 세제 혼합 금지, 보호장비 착용, 환기 필수, 어린이 손 닿지 않는 곳 보관, 환경부 안전확인 마크 확인
결론

곰팡이 제거제는 이제 제습기를 넘어선 '곰팡이 킬러'로 자리 잡았습니다.
2023년에서 2025년 실험 및 소비자 데이터를 바탕으로 안전성, 경제성, 성능을 종합적으로 고려해 제품을 선택한다면
올여름 곰팡이 걱정 없는 쾌적한 생활이 가능해집니다.
'정보전달' 카테고리의 다른 글
| 실패 없는 망고 고르는 법: 2025년 최신 가이드 (2) | 2025.06.21 |
|---|---|
| 하루 몇 번 발라야 효과적인가? 선크림 사용법의 과학적 진실 (0) | 2025.06.21 |
| 닭볶음탕 vs 닭도리탕, 무엇이 다를까? 어원부터 맛까지 완벽 정리 (0) | 2025.06.20 |
| 스마트폰, 아이에게 해로운 독인가 유익한 도구인가? (1) | 2025.06.20 |
| 여름철 전기요금 폭탄, 90%는 이 습관 때문입니다 (0) | 2025.06.19 |